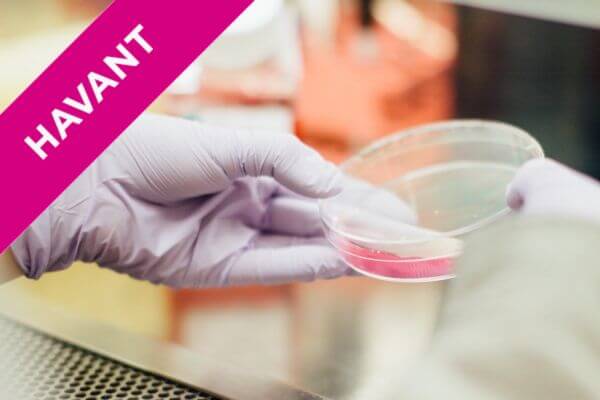
a person with gloves on holding a petri dish with chemical inside

Showing results 41 - 60 of 65
Introduction to Programming Level 1 - Alton APY-PROG1A/C01
- Qualification
Level 1 Award
- Type of study
Part Time
- Venue
Alton Campus
Level 1 Award
Part Time
Alton Campus
The Level 1 Award in Introduction to Programming at Alton College is a 12-week part-time daytime course covering programming fundamentals and practical coding skills, providing a strong foundation for further digital and technical study.
Introduction to Programming Level 1 - Havant HPY-PROG1A/C01
- Qualification
Level 1 Award
- Type of study
Part Time
- Venue
Havant Campus
Level 1 Award
Part Time
Havant Campus
The Level 1 Award in Introduction to Programming at Havant Campus is a 12-week part-time daytime course covering programming fundamentals and practical coding skills, providing a strong foundation for further digital and technical study.
Introduction to Programming Level 2 - Alton APY-PROG2A/C01
- Qualification
Level 2 Award
- Type of study
Part Time
- Venue
Alton Campus
Level 2 Award
Part Time
Alton Campus
The Level 2 Award in Computer Programming at Alton College introduces core programming principles and practical coding skills. Learners create text-based programs and develop a strong foundation for further study and digital careers.
Introduction to Programming Level 2 - Havant HPY-PROG2A/C01
- Qualification
Level 2 Award
- Type of study
Part Time
- Venue
Havant Campus
Level 2 Award
Part Time
Havant Campus
The Level 2 Award in Computer Programming at Havant Campus introduces core programming principles and practical coding skills. Learners create text-based programs and develop a strong foundation for further study and digital careers.
Lead Engineering Maintenance Technician Apprenticeship Level 4 SAA-LEMTL4/P01
- Qualification
Level 4 Higher Apprenticeship Standard
- Type of study
Apprenticeships
- Venue
South Downs Campus
Level 4 Higher Apprenticeship Standard
Apprenticeships
South Downs Campus
This Level 4 apprenticeship develops engineering maintenance and leadership skills, covering installation, overhaul, testing, inspections and commissioning of systems and machinery through workplace training and weekly college study.
Mathematics (Further) HF1-MATFAL/C01
- Qualification
A Level
- Type of study
A Levels
- Venue
Havant Campus
A Level
A Levels
Havant Campus
Further Mathematics is a challenging A Level studied alongside Mathematics, expanding your skills through advanced topics. It suits confident mathematicians and supports progression to degrees such as engineering, physics, computer science, economics and mathematics.
Mathematics A Level HF1-MATHAL/C01
- Qualification
A Level
- Type of study
A Levels
- Venue
Havant Campus
A Level
A Levels
Havant Campus
A Level Mathematics develops strong problem-solving and logical thinking skills through the study of pure maths, mechanics and statistics. It suits confident mathematicians and supports progression to subjects such as science, economics, psychology and computer science.
Mathematics A Level (Alton) AF1-MATHAL/C02
- Qualification
A Level
- Type of study
A Levels
- Venue
Alton Campus
A Level
A Levels
Alton Campus
A Level Mathematics at Alton College builds on GCSE skills and introduces new topics including calculus, exponentials, series and advanced probability. You will develop data analysis skills, explore statistical models and study mechanics, covering forces, motion and vectors.
Mathematics and Further Mathematics A Level (Alton) AF1-MATFAL/C01
- Qualification
A Level
- Type of study
A Levels
- Venue
Alton Campus
A Level
A Levels
Alton Campus
A Level Further Mathematics at Alton College allows you to study advanced mathematical concepts alongside A Level Mathematics. You will explore complex numbers, conic sections, advanced geometry and differential equations. This challenging course is ideal for strong mathematicians aiming for degrees in engineering, physics, economics or computing.
Maths Functional Skills DPY-MATHNO/P01
- Qualification
Part Time
- Type of study
Functional Skills
- Venue
Other Venue
Part Time
Functional Skills
Other Venue
Functional Skills Maths helps adult learners (18+) improve their confidence and skills in everyday mathematics. After an initial assessment, you will work from Entry Level up to Level 2 through step-by-step units. The course covers number, measurement, shape, space and data to support progression into GCSE Maths or employment.
Maths GCSE - Alton College APY-MATHGC/C01
- Qualification
GCSE
- Type of study
GCSE
- Venue
Alton Campus
GCSE
GCSE
Alton Campus
This revision course gives you the chance to significantly enhance your Higher Education or career prospects.
Maths GCSE - Havant Campus HPY-MATHGC/C01
- Qualification
GCSE
- Type of study
GCSE
- Venue
Havant Campus
GCSE
GCSE
Havant Campus
GCSE Maths at Havant Campus is designed to build your confidence and strengthen your understanding of key topics such as algebra and statistics. The course is suitable for adults aged 18+ who want to improve their grade, with Foundation and Higher options available depending on your previous results. You will study number, algebra, geometry, probability and ratio to prepare for the final exams.
Mechatronics Maintenance Technician Apprenticeship Level 3 SAA-MMTEL3/P01
- Qualification
Level 3 Advanced Apprenticeship Standard
- Type of study
Apprenticeships
- Venue
South Downs Campus
Level 3 Advanced Apprenticeship Standard
Apprenticeships
South Downs Campus
This new Level 3 apprenticeship develops the technical skills and knowledge needed to maintain, fault-find and repair complex mechatronic systems across modern engineering environments.
Medical Science ALMP HF1-MESC3T/C01
- Qualification
Level 3 Diploma
- Type of study
Vocational
- Venue
Havant Campus
Level 3 Diploma
Vocational
Havant Campus
This applied science course focuses on real-world medical contexts, preparing students for healthcare careers such as nursing, radiography and paramedic science.
Physics HF1-PHYSAL/C01
- Qualification
A Level
- Type of study
A Levels
- Venue
Havant Campus
A Level
A Levels
Havant Campus
This two-year A Level develops strong problem-solving and analytical skills through the study of everything from particles and quantum physics to stars and galaxies, with real-world applications in energy, technology and medical imaging—excellent preparation for engineering, physics, medicine and other STEM degrees.
Physics A Level (Alton) AF1-PHYSAL/C01
- Qualification
A Level
- Type of study
A Levels
- Venue
Alton Campus
A Level
A Levels
Alton Campus
This two-year A Level explores physics from sub-atomic particles to the scale of the universe, combining strong mathematical skills with practical investigation. You’ll study forces, waves, electricity, quantum and particle physics, astrophysics and medical imaging, building excellent preparation for degrees and careers in engineering, physics, health sciences, technology and related STEM fields.
Science GCSE Suite (5 GCSEs) SFY-GCSEFT/P01
- Qualification
GCSE
- Type of study
Vocational
- Venue
South Downs Campus
GCSE
Vocational
South Downs Campus
A one-year GCSE programme at South Downs Campus providing focused study in five subjects, including English and Maths, to help students achieve key grades for progression to science-based T Levels or A Levels, with a mix of taught lessons and practical investigations.
Understanding Environmental Sustainability - Level 2 Certificate HD1-UENV2C/C01
- Qualification
Distance Learning Level 2 Certificate
- Type of study
Online Learning
- Venue
Online
Distance Learning Level 2 Certificate
Online Learning
Online
This Level 2 online course explores environmental sustainability, covering climate change, carbon reduction, renewable energy, conservation, waste management, and sustainable practices.
Vehicle Maintenance & Repair - Motorsport - Level 1/2 SF1-LVMR1D/C01
- Qualification
Level 1/2 Diploma
- Type of study
Vocational
- Venue
South Downs Campus
Level 1/2 Diploma
Vocational
South Downs Campus
This two-year Level 1-2 course covers vehicle electrical and mechanical systems, motorsport event regulations, workshops, diagnostics, and essential skills in numeracy, communication, and ICT.
Vehicle Systems - Entry Level SFY-VESM0D/C01
- Qualification
Entry Level Diploma
- Type of study
Vocational
- Venue
South Downs Campus
Entry Level Diploma
Vocational
South Downs Campus
This one-year Entry Level course covers vehicle repair and maintenance, including engines, brakes, electrical systems, suspension, and practical workshop skills, alongside English and Maths Functional Skills.